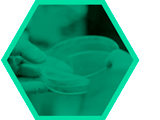

Pillar I: Early Metabolic Injury
When does a fatty liver really develop a disorder?
One of the tasks of the healthy liver is to store fat. Yet, at some stage, too much fat makes the liver sick. One critical time point occurs when a healthy fatty liver becomes inflamed and progresses to steatohepatitis, or NASH.
LiSyM-Pillar I will identify what events lead to this transition. Does it occur in all parts of the liver? Which molecules indicate that it is taking place? Can the degeneration be stopped or undone - and if so, how?
Read more: Zones of the liver accumulate fat at different rates